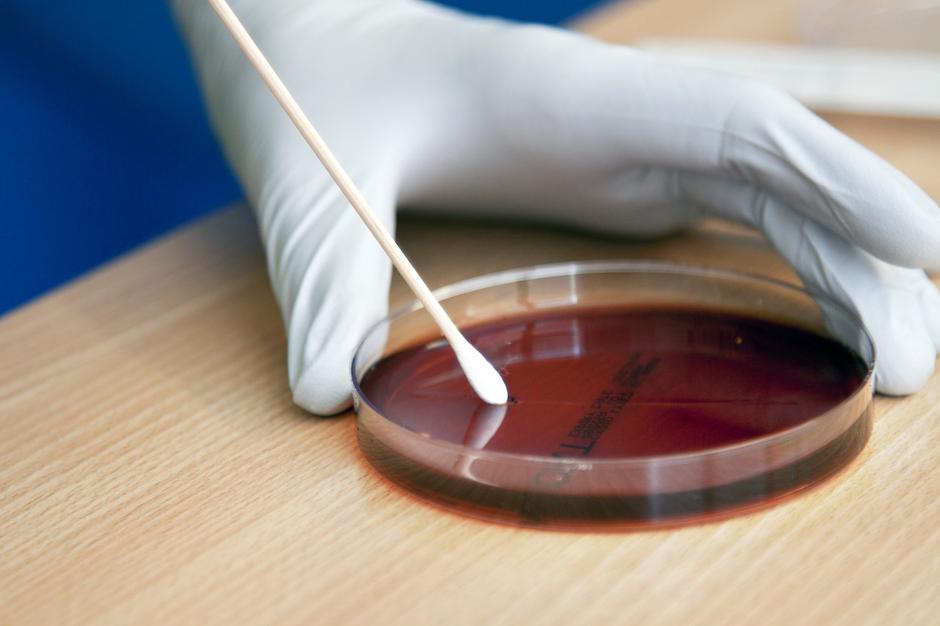
Neisseria meningitidis bakterija | Avtor: Profimedia

Epidemiološka služba NIJZ je bila v nedeljo dopoldne obveščena o primeru invazivnega meningokoknega meningitisa. Pacienta srednjih let so v soboto pripeljali v bolnišnico v Murski Soboti, kjer je še isti dan umrl, je povedal Zoran Simonović, predstojnik območne enote Nacionalnega inštituta za javno zdravje Maribor.
Po potrditvi laboratorijske okužbe je NIJZ začel z epidemiološkim poizvedovanjem. Začeli so z iskanjem vseh tesnih kontaktov, ki jih je bilo treba identificirati in zaščititi z zdravilom. Identificiranih je bilo 68 tesnih kontaktov, ki so bili v tako tveganem stiku s pacientom, da je bila potrebna zaščita z zdravili. Za vse ostale, ki so morda imeli bežen stik s pacientom, posebni ukrepi niso potrebni.
Pri nas so v zadnjih 10 letih potrdili 101 primer tovrstne meningokokne okužbe, od tega je sedem oseb umrlo. Zadnja dva potrjena smrtna primera pri nas pred tem sta bila v letu 2018. V približno 7 odstotkih primerov se bolezen kljub ustreznemu zdravljenju konča tragično.
Vir okužbe v tem primeru še ni znan. Simonovič je pojasnil, da je običajno vir zdrav nosilec. Približno 5 do 10 % odstotkov ljudi nosi to bakterijo, ki jim ne povzroča težav, lahko pa jo prenesejo na dovzetne posameznike. Dovzetnost je večja pri osebah z okrnjenim imunskim stanjem, pomanjkanjem komplementa in pri osebah brez vranice.
Okužba poteka zelo hitro. Običajno se začne z visoko temperaturo, glavobolom, slabostjo, bruhanje. Prihaja do motenj zavesti, stanje pa se spreminja zelo hitro. Kljub hitremu antibiotičnemu zdravljenju se bolezen v 8 do 15 % primerov konča s smrtjo.
Meningokokne bakterije se prenašajo kapljično ob tesnem kontaktu. Za prenos je potreben tesen stik s pacientom ali z nosilcem bakterije. Pod tesen stik se običajno smatrajo tisti, ki so v intimnem tesnem kontaktu z bolnikom na razdalji 1,5 metra ali manj. V to običajno sodijo ožji družinski člani, zaposleni v zdravstvu, ki so prišli v stik z bolnikom, in eventuelno osebe, kot so sodelavci v kolektivu, ki so imeli tesnejši stik.
Pri nas so v zadnjih 10 letih potrdili 101 primer tovrstne meningokokne okužbe, od tega je sedem oseb umrlo. V približno 7 odstotkih primerov se bolezen kljub ustreznemu zdravljenju konča tragično.
V EU je letno potrjenih nekaj tisoč primerov, je povedal Simonović. V svetu so določena področja, kjer je tveganje za okužbe večje. Vsem, ki potujejo v subsaharsko Afriko, tako priporočajo, da se pred odhodom cepijo.
Obstaja cepivo
Proti okužbi z bakterijo Neisseria meningitidis se je mogoče cepiti. Obstaja več vrst cepiva, pri nekaterih sta potrebna dva odmerka. V Sloveniji se cepi približno 1.500 oseb letno. Cepljenje je priporočeno za vse osebe z okrnjeno imunostjo in osebe, ki so brez vranice, ter nekatere osebe po transplantaciji kostnega mozga.
V Sloveniji sta na voljo dve cepivi. Eno je štirivalentno proti štirim skupinam meningokokov, drugo pa je monovalentno, vsebuje zaščito proti meningokokom skupine B, ki so najpogostejši, in je za samoplačnike na voljo od leta 2020. Z njim se lahko cepijo dojenčki od drugega meseca starosti, dojenčki potrebujejo tri odmerke. Cena enega odmerka tega cepiva v ambulanti za potovalno medicino stane 96 evrov, kar pomeni, da je celotni strošek cepljenja 196 oziroma 288 evrov. Cena cepiva za štirivalentno cepivo ACWY je 46 evrov, potreben je le en odmerek. V trboveljskem zdravstvenem domu je cena enega odmerka za B 86 evrov.
Bolezen s hitrim in agresivnim potekom
Meningokokna okužba je najpogostejši vzrok za vnetje možganskih ovojnic pri dojenčkih, otrocih do 4. leta in najstnikih. Gre za bolezen, ki ima hiter in agresiven potek, širi se predvsem kapljično s kašljanjem, kihanjem in poljubljanjem, prenašajo jo na videz zdravi ljudje, ki to bakterijo prenašajo v nosno-žrelnem prostoru. Invazivna meningokokna okužba lahko močno napreduje v nekaj urah. Najpogostejša je med otroki in najstniki, vendar lahko prizadene vse starostne skupine. V zgodnjih stanjih se zdravi z antibiotiki, a ko bolezen napreduje, pomoči ni.
Leta 2016 je dveletni Anej zaradi okužbe z meningokoknim meningitisom umrl v enem dnevu. V soboto je bil še povsem zdrav, v nedeljo zjutraj pa se je zbudil s temperaturo, bruhal je in imel drisko. V dežurni ambulanti so mami svetovali, da mu zbija vročino in mu daje piti po požirkih, saj se bolezen v začetku ne loči od viroze. Popoldne so se pojavili izpuščaji in starši so otroka odpeljali k dežurnemu zdravniku na Ravnah na Koroškem, od tam takoj v slovenjgraško bolnišnico, kjer so odredili nujen prevoz v Ljubljano. Tam je deček zaradi meningokoknega meningitisa tipa B, kmalu po sprejemu umrl.
Gre sicer za redko bolezen, ki se začne nenadoma in z nespecifičnimi simptomi, kot so nenadna visoka vročina, bolečine v mišicah, glavobol, pogostim bruhanjem in otrdelim vratom. Značilen je pojav izpuščaja na koži v obliki drobnih krvavitev (petehije). Bolezen je imela včasih zelo visoko smrtnost, z uporabo antibiotikov se je ta precej zmanjšala, vendar je še vedno visoka (8-15%). Okužba lahko v nekaj urah napreduje v motnjo zavesti, krče in značilen petehialni izpuščaj na koži. Ker se tipični znaki pojavijo relativno pozno, je bolezen v zgodnji fazi težko prepoznati. V okoli petini primerov lahko bolezen pusti trajne posledice, kot so okvare možganov, amputacija udov in izguba sluha.






🍓 Vroča dekleta čakajo na vas na 👉 𝗦𝗲𝘅𝘁𝗼.𝗹𝗶𝗳𝗲
Če imaš smolo, te nihče ne reši. Tega se je dobro zavedati vsak dan posebej. Še zdaleč ni vsako stanje ozdravljivo, tudi če si še relativno mlad.
Če jo prepozno začnemo zdraviti je prepozno! Vsaka minuta šteje za postavitev diagnoze!